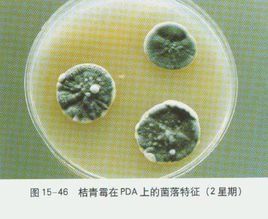
青黴 青黴

簡介
青黴青黴(拼音 :qīng méi),一般指青黴屬(Penicillium)。和麴黴屬有親緣關係,有二百幾十種,代表種是灰綠青黴(Penicillium glaucum),從土壤或空氣中很易分離,分枝成帚狀的分生孢子從菌絲體伸向空中,各頂端的小梗產生鏈狀的青綠—褐色的分生孢子。根據分生孢子頂端的膨大與否,與麴黴屬(AsPergillus)相區別。其語源來自其形狀(帚狀,Penicillus)。子囊殼為封閉型。該屬菌產生一種特殊物質。自從弗萊明(A.Fleming,1929)發現特異青黴(Penicillium notatum)產生抑制細菌生長物質青黴素以來,已對該屬菌的很多種進行了研究。特異青黴已被用於製造青黴素,但不具這種生產機能的種還很多,同時,其生產也並不限於青黴屬。已知在生理學方面類似麴黴屬,同時有很多能產生毒枝菌素(mycotoxin)。
青黴菌屬多細胞,營養菌絲體無色、淡色或具鮮明顏色。菌絲有橫隔,分生孢子梗亦有橫隔,光滑或粗糙。基部無足細胞,頂端不形成膨大的頂囊,其分生孢子梗經過多次分枝,產生幾輪對稱或不對稱的小梗,形如掃帚,稱為帚狀體。分生孢子球形、橢圓形或短柱形,光滑或粗糙,大部分生長時呈藍綠色。有少數種產生閉囊殼,內形成子囊和子囊孢子,亦有少數菌種產生菌核。
青黴的孢子耐熱性較強,菌體繁殖溫度較低,酒石酸、蘋果酸、檸檬酸等飲料中常用的酸味劑又是它喜愛的碳源,因而常常引起這些製品的霉變。
概述
生活習性
青黴通常在柑桔及其他水果上,冷藏的乾酪及被它們的孢子污染的其他食物上均可找到,其分生孢子在土壤內,空氣中及腐爛的物質上到處存在.青黴營腐生生活,其營養來源極為廣泛,是一類雜食性真菌,可生長在任何含有機物的基質上.
形態
青黴的營養體為無色或淡色的菌絲體,菌絲各細胞之間有橫隔膜,細胞內通常為多核.整個菌絲體分為伸入營養基質中吸取營養的基質菌絲和伸向空氣中的氣生菌絲.在氣生菌絲上產生簡單的長而直立的分生孢子梗,頂端以特殊的對稱或不對稱的掃帚狀的方式分支,稱為帚狀枝.分支為多極的分生孢子梗最後產生許多瓶梗,在瓶梗上著生分生孢子鏈.分生孢子為球形至卵形,呈綠色,藍色或黃色,即通常看到的各種青黴菌落特有的顏色.
生活史
自然界中已發現的青黴絕大多數以無性繁殖的方式繁衍後代,即分生孢子萌發為菌絲體,在氣生菌絲上產生分生孢子梗,在分生孢子梗上串生許多分生孢子,分生孢於在適宜環境中又萌發為菌絲體,以此循環反覆.
青黴中有極少數種類行有性生殖.其過程為:從營養菌絲上產生雄器和產囊體→雄器頂端與產囊體接觸處細胞壁溶解→質配→核配→減數分裂後(一般推測)形成子囊.在此過程中,由產囊體周圍營養菌絲逐步包圍形成子囊果.當子囊孢子成熟後被釋放,在適宜環境中萌發形成新的菌絲體.但不同種青黴其性行為變異很大.有些種雄器似乎沒有功能,在原生質體互相接觸後,沒有發生核的遷移,產囊體內成對的核起源於原來產囊體的核.
分類
青黴屬於麴黴科(Eurotiaceae).青黴和麴黴都為常見屬,二者的主要鑑別特徵是孢子梗的排列不同.麴黴的孢子梗是輻射狀排列,呈頭狀. 青黴與人類生活息息相關.少數種類能引起人和動物的疾病;許多種青黴能造成柑桔,蘋果,梨等水果的腐爛;對工業產品,食品,衣物也造成危害;在生物實驗室中,它也是一種常見的污染菌.加強通風,降低溫度,減少空氣相對濕度,可以大大減輕青黴的危害. 但在另一方面,青黴對人類非常重要,在工業上,它可用於生產檸檬酸,延胡索酸,葡萄糖酸等有機酸和酶製劑;非常名貴的婁克馥乾酪,丹麥青乾酪都是用青黴釀製而成的;最著名的抗生素——青黴素就是從青黴的某些品系中提取而來,它是最早發現,最先提純,臨床上套用最早的抗生素;當前發現的另一重要抗生素——灰黃黴素,是由灰黃青黴產生的,是抑制諸如腳癬之類的真菌性皮膚病的最好抗生素.
藥用價值
青黴素化學結構式青黴素(Benzylpenicillin / Penicillin)又被稱為青黴素G、peillin G、 盤尼西林、配尼西林、青黴素鈉、苄青黴素鈉、青黴素鉀、苄青黴素鉀。青黴素是抗菌素的一種,是指從青黴菌培養液中提制的分子中含有青黴烷、能破壞細菌的細胞壁並在細菌細胞的繁殖期起殺菌作用的一類抗生素,是第一種能夠治療人類疾病的抗生素。青黴素類抗生素是β-內醯胺類中一大類抗生素的總稱。
1928年英國細菌學家弗萊明首先發現了世界上第一種抗生素—青黴素,1941年前後英國牛津大學病理學家霍華德·弗洛里與生物化學家錢恩實現對青黴素的分離與純化,並發現其對傳染病的療效,弗萊明、弗洛里、錢恩三人共同獲得1945年諾貝爾獎。當前所用的抗生素大多數是從微生物培養液中提取的,有些抗生素已能人工合成。由於不同種類的抗生素的化學成分不一,因此它們對微生物的作用機理也很不相同,有些抑制蛋白質的合成,有些抑制核酸的合成,有些則抑制細胞壁的合成。
化學本質:鹽酸巴氨西林。其化學名為1-乙氧甲醯乙氧6-〔D(-)-2-氨基-2-乙醯氨基〕青黴烷酸鹽酸鹽。
分子式:C16H18N2O4S·HCl
分子量:384.5
CAS號:61-33-6
EINECS號:200-506-3
InChI編碼:InChI=1/C16H18N2O4S/c1-16⑵12(15(21)22)18-13⒇11(14⒅23-16)17-10⒆8-9-6-4-3-5-7-9/h3-7,11-12,14H,8H2,1-2H3,(H,17,19)(H,21,22)/t11-,12+,14-/m1/s1青黴素它不能耐受耐藥菌株(如耐藥金葡)所產生的酶,易被其破壞,且其抗菌譜較窄,主要對革蘭氏陽性菌有效。青黴素G有鉀鹽、鈉鹽之分,鉀鹽不僅不能直接靜注,靜脈滴注時,也要仔細計算鉀離子量,以免注入人體形成高血鉀而抑制心臟功能,造成死亡。
下級分類
類麴黴亞屬Aspergilloides
叉狀亞屬Furcatum
青黴亞屬Penicillium
雙輪亞屬 Biverticillium, Dierckx